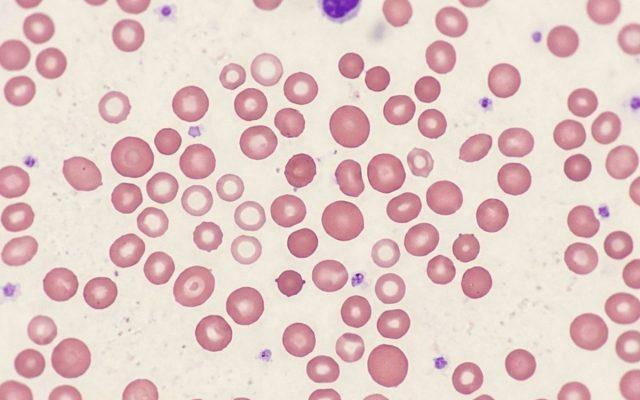

Du musst kein Medizinprofi sein, um deine Blutwerte zu verstehen!
Auf dieser Seite findest du verständliches Wissen über deine Blutwerte (Laborwerte). Einige davon tauchen irgendwann auf deinem Laborzettel (Blutbefund) auf und verunsichern dich vielleicht. Diese Artikel sollen dir als Unterstützung dienen, deine Werte besser einzuorden und zu verstehen. Ich als ganzheitliche Ärztin habe die Mission dir deine Blutwerte näherbringen. Ich möchte dir zeigen, dass JEDER lernen kann seinen Laborbefund zu lesen. Denn das Medium Blut ist wundervoll dafür geeignet, Symptome und Gesundheit zu „lesen“.
Viel Freude damit!